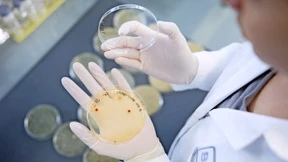
Kampf gegen Krebs und Fettleibigkeit

Studie zur Abnehmspritze Survodutid lässt Boehringer hoffen
Das Mittel Survodutid soll nicht nur Menschen mit Adipositas, sondern auch Patienten mit schweren Lebererkrankungen helfen. Nun stellt Boehringer Ingelheim erste Ergebnisse vor.

Das Durchschnittsgewicht der Deutschen ist in den vergangenen Jahren gestiegen – an der Durchschnittsgröße hat sich hingegen kaum etwas geändert. Eine Umfrage zeigt die genauen Zahlen.

Das Mittel Survodutid soll nicht nur Menschen mit Adipositas, sondern auch Patienten mit schweren Lebererkrankungen helfen. Nun stellt Boehringer Ingelheim erste Ergebnisse vor.

Andreas Michalsen erklärt, wie sich eine eiweißarme Ernährung auf das Frakturrisiko auswirkt, warum die Datenlage zu Milch und Knochengesundheit verwirrend ist – und welche Sportarten als Osteoporoseprävention taugen.

Wer zu viel wiegt, hat ein höheres Risiko für Bluthochdruck, Diabetes und andere chronische Erkrankungen. Nun wird ein weiterer Gesundheitsnachteil erforscht.

In Großbritannien steht Premierminister Keir Starmer wegen des Epstein-Skandals unter Druck. Eine Studie belegt, wie Übergewicht das Risiko von Infektionskrankheiten erhöht. Und bei Olympia tritt Alpin-Ass Emma Aicher abermals an. Der F.A.Z. Frühdenker.

Der Schweizer Pharmakonzern erzielt positive Ergebnisse in einer Phase-II-Studie, der Aktienkurs hat seit Jahresbeginn deutlich angezogen. Analysten sehen in dem umkämpften Markt allerdings auch Hürden.

Hochverarbeitete Nahrung führt zu Übergewicht und Krankheiten wie Diabetes Typ 2. Es fällt aber nicht leicht, Fruchtjoghurts, Fertiggerichte oder Limonaden vom Speiseplan zu streichen. Wie die Lebensmittelindustrie uns austrickst.

Unser Kolumnist ist Landarzt. Auch er verschreibt seinen Patienten die sogenannte „Abnehmspritze“. Damit sie auch wirklich erfolgreich Gewicht verlieren, gibt er immer noch einen Rat dazu.

Auf der Welt sind mehr Kinder fettleibig als untergewichtig. Nahezu überall werden die Kinder immer dicker. Das zeigt ein aktueller Bericht von UNICEF. Schuld ist die moderne Ernährung. Doch die Politik bleibt untätig – auch in Deutschland.

Feste Mahlzeiten und traditionelle Essgewohnheiten fallen aus der Mode. Eine neue Studie zeigt, wie Individualisierung, „Snacking“ und Selbstoptimierung das Ernährungsverhalten prägen – und welche Herausforderungen daraus entstehen.


Zucker wirkt im Gehirn wie eine Droge, heißt es. Das stimmt so nicht ganz. Forscher erklären, warum wir übermäßig viel Lust auf Süßes haben – auch wenn wir satt sind. Und wie es gelingt, weniger davon zu essen.

Am Bauch ist Fett ungünstiger als an anderen Körperstellen. Eine Ärztin erklärt, wann es gesundheitlich bedenklich wird – und was man essen sollte, wenn man es loswerden will.

Trotz leichter Fortschritte in der Fitness sind Grundschulkinder in Baden-Württemberg so übergewichtig wie nie zuvor. Was hinter dem Trend steckt – und was Experten fordern.

Herz-Kreislauf-Erkrankungen gehören zu den häufigsten Todesursachen. Wer die Big Five der Risikofaktoren meidet, hat eine Chance darauf, mehr als ein Jahrzehnt länger zu leben.

Wie bewegt sich mein Körper im Raum? Wie balanciere ich mich aus? Kinder lernen beim Klettern fürs Leben, überwinden Ängste und stärken Vertrauen. Der perfekte Sport? Eigentlich – aber nicht für jeden.

Übergewicht wird trotz Kritik mit dem BMI gemessen. Eine Alternative wäre der Body-Roundness-Index. Der Ernährungsmediziner Manfred J. Müller erklärt seine Vorteile und Tücken.

Amerikas künftiger Gesundheitsminister Kennedy will Kinder vor zu viel Zucker schützen. Auch in Deutschland muss mehr getan werden, vor allem in bildungsfernen Milieus. Aber vielleicht nicht gleich an Weihnachten.

Der Pharmakonzern beschleunigt die Entwicklung seiner Pille gegen Übergewicht. Um den großen Rivalen Novo Nordisk und Eli Lilly Marktanteile abzujagen, braucht es aber einen Zusatznutzen. Und den wollen die Schweizer liefern.

Elena und Ingmar lassen sich zum zweiten Mal den Magen verkleinern, um abzunehmen. Wer das für eine einfache Lösung hält, hat keine Ahnung.

Die Deutschen werden immer dicker, doch Wohnungen und Möbel wachsen nicht mit. Wie starkes Übergewicht den Alltag und das Wohnen zur Belastungsprobe macht.

Anlagen auf den bekannten Weltaktienindex stehen in der Kritik, zu amerika- und technologielastig zu sein. Doch gerade diese Übergewichtung hat einen entscheidenden Vorteil. Die Finanzen-Kolumne „Über Rendite“.

Neun Bundesländer fordern eine Zuckersteuer auf Erfrischungsgetränke. Würde das dafür sorgen, dass Verbraucher weniger davon trinken? Die FDP hält das für eine „Scheinlösung“. Und ein Blick in andere Länder zeigt: Es kommt drauf an, wie man es macht.

Nicht rauchen, keinen Alkohol trinken und sich gesund ernähren sind die Klassiker der Krebsprävention. Auch das Körpergewicht im normalen Bereich zu halten gehört dazu – denn zu viele Kilos auf den Rippen steigern das Risiko, an einem Tumor zu erkranken, in erheblichem Maße. Doch der Zusammenhang wird noch immer unterschätzt.

Neue Medikamente gegen Diabetes und Übergewicht haben Eli Lilly zum wertvollsten Pharmakonzern der Welt gemacht. Alexander Horn von der deutschen Tochtergesellschaft spricht über das geplante Werk in Alzey, Hürden bei der Vermarktung in Deutschland und die Konkurrenz zu Novo Nordisk.

Starkes Übergewicht, Mondgesicht und Stiernacken sind Anzeichen des Cushing-Syndroms. Verursacht wird es durch einen Überschuss des Hormons Cortisol. Forscher aus Gießen und München haben sich dies für eine einfachere Diagnose zunutze gemacht.

Der dänische Konzern profitiert von der hohen Nachfrage nach seinen Medikamenten gegen Diabetes und Fettleibigkeit. Das Ausmaß des Erfolgs überrascht Analysten.

Die Medikamente von Novo Nordisk sind die Hoffnung vieler Übergewichtiger. Andere Hersteller bangen nun um ihre Produkte.

Der Body-Mass-Index bestimmt, ob man zu dick oder zu dünn ist. Er gilt als Indikator, wie gesund jemand ist. Doch dazu taugt er gar nicht.

Die neuen Abnehmspritzen lassen die Pfunde schmelzen. Mediziner sprechen von einer „Revolution“ bei der Behandlung von Übergewicht. Wie steht es um die Nebenwirkungen?

Immer mehr Menschen sind adipös. Eine Betroffene erzählt von ihrer Kindheit, von Depressionen und darüber, was Adipöse vor allem brauchen.

Jedes Jahr sterben mehr Menschen in Europa an den Folgen von Übergewicht als an Corona. Und doch sagen Aktivisten: alles kein Problem.

Der dänische Pharmakonzern Novo Nordisk löst den französischen Luxushersteller LVMH als wertvollsten Konzern Europas ab. Das Unternehmen profitiert von Mitteln, die gegen die Volkskrankheit Fettleibigkeit helfen soll.

Viele Eltern legen inzwischen Wert darauf, ihre Kinder komplett zuckerfrei zu ernähren. Warum das gar nicht nötig ist und worauf es stattdessen ankommt, erklärt eine Forscherin im Interview.

Mehr als die Hälfte der Deutschen sind übergewichtig, jeder fünfte gilt als adipös. Kann ein nun auch in Deutschland zugelassenes Medikament helfen, dieses Problem in den Griff zu bekommen?
Bewegungsmangel und schlechte Ernährung führen zu extrem starkem Übergewicht. Immer mehr Kinder sind betroffen, die Beschränkungen während der Corona-Pandemie haben die Entwicklung offenbar verstärkt.
Eine schonende Alternative zur Magenverkleinerung: Diese Geschäftsidee hat beim Science4Life-Wettbewerb den ersten Platz erobert.

Die weltweit häufigste Ursache für Arbeitsunfähigkeit sind Schmerzen im unteren Rücken. Das liegt nicht nur an schwerer Arbeit und schlechten Arbeitsplätzen – sondern auch am Rauchen.